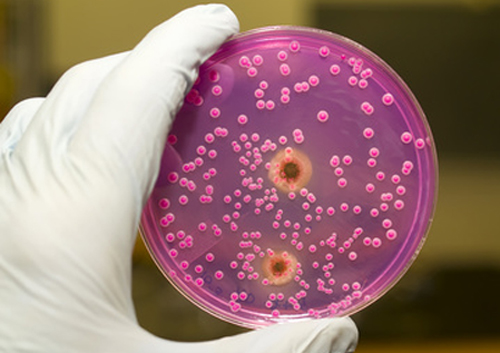

В интернате сальмонеллез
В предыдущем номере мы писали о 16 воспитанниках Борзнянской специализированной школы-интерната I-III ст. с углубленным изучением отдельных предметов и курсов, которые попали в Борзнянскую ЦРБ с подозрением на острую кишечную инфекцию. Шестерым из них диагностировал и сальмонеллез (инфекционное заболевание, которое вызывают бактерии рода Salmonella). Результаты анализов остальных еще не готовы: часть анализов делают в местной лаборатории, часть — в Чернигове.
Бактерии сальмонеллы на лабораторном стекле
— Новых случаев заболевания за это время не было. Все 16 пациентов и сейчас находятся в нашей больнице. У всех состояние удовлетворительное, — говорит главный врач Борзнянской ЦРБ Татьяна Стовба.
Сальмонелла - это особый вид бактерий, которые при попадании в организм человека приводят к воспалению некоторых отделов пищеварительной системы и выраженной интоксикации.
Сальмонеллы имеют определённые особенности:
Екатерина Дроздова, «Гарт» №10 (2867) от 8 марта 2017
Хочете отримувати головне в месенджер? Підписуйтеся на наш
Telegram.




